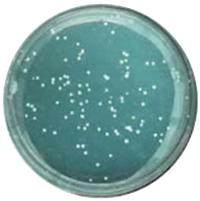

お部屋の空気
〈標準仕様〉
《FFCテクノロジー》
美味しい空気を
感じられる家
現代に多い不健康ハウス。
VOC(揮発性有機化合物)・ハウスダストの発生によるシックハウス症候群や、
過度な無菌加工による免疫力低下など、
家の空気の汚染・無菌環境が
健康被害をもたらします。
健康免疫住宅は
FFC®テクノロジーを採用。
住む人の免疫力を高めて
健康へ導く、
美味しい空気の家なのです。
FFC®
テクノロジーとは
FFC®テクノロジーは、木材・建材・クロス等の素材に含まれる水分に水溶性の2種類の鉄を含浸させる技術です。
FFC®テクノロジーを活用することで、
悪影響を及ぼす化学物質の害を最小限に抑えることが出来ます。

FFC®
テクノロジー
4つの効果
効果1
嫌な臭いが出ない
シックハウス症候群の一因と考えられているVOC(揮発性有機化合物)を分解するので、新築・改築時のクロスや接着剤の嫌な臭いがしません。
効果2
アレルギー症状を
抑える
健康維持に必要な善玉常在菌は増殖し、
悪影響をあたえる悪玉菌は減少します。
効果3
マイナスイオン効果で
快適
マイナスイオンは化学物質や悪臭を中和します。また花粉やカビがと結びついて落下するので、お掃除で取り除くことが出来ます。
効果4
人の角質細胞が活性化
FFC®環境下では角質細胞が活性化されて、皮膚を健康に保ちます。
FFC®活用の
木材における
細菌の増殖実験
FFC®活用により、悪玉菌であるMRSAの増殖を抑制させることが確認されました。
FFC®活用により、乳酸菌桿菌類などの有益な菌は増殖することが確認されました。
空気中の
イオン数の測定
マイナスイオン
外気と比較してFFC®処理された室内でのマイナスイオンが倍増して発生することが確認されました
プラスイオン
通常ではマイナスイオンの増加と比例して起こるプラスイオンの増加が抑えられた事が、研究の測定で実証されました。
角質細胞活性化の
実験
FFC®木片はヒトの角質細胞を2倍に促進し、分化も促進。色素芽細胞も2倍に増殖させます。
FFC®の木に囲まれていると皮膚の細胞の入れ替わりが促進され、皮膚が健康に保たれる可能性が大きいと言えます。